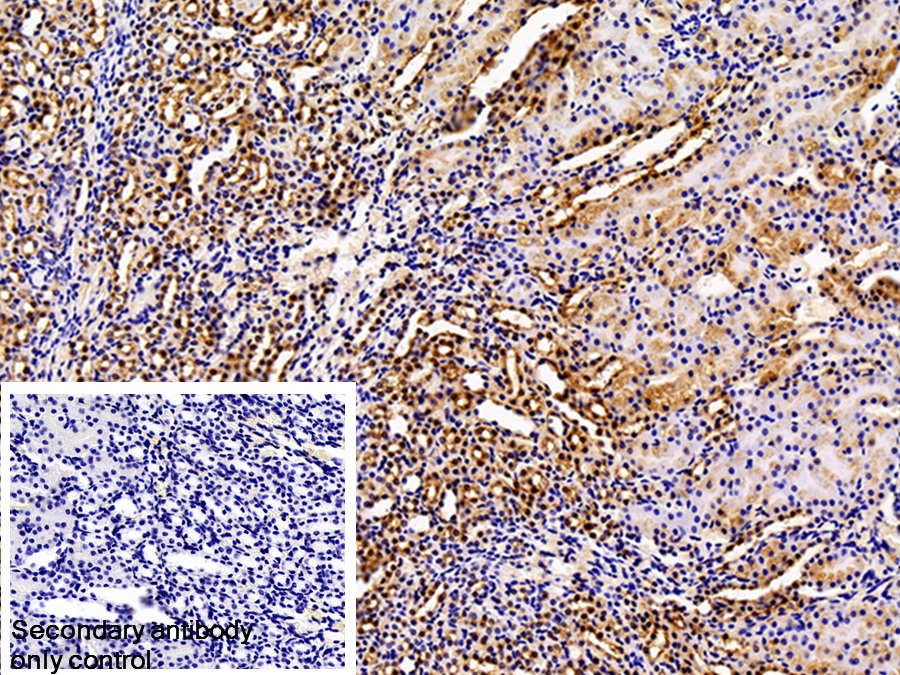

S100钙结合蛋白(S100)多克隆抗体
Polyclonal Antibody to S100 Calcium Binding Protein (S100)
S100-A1; S100A1; S100-Alpha; S-100 Protein; S-100 protein subunit alpha; S-100 protein alpha chain
- 编号PAA012Mu01
- 物种Mus musculus (Mouse,小鼠)相同的名称,不同的物种。
- 来源多抗制备
- 宿主兔
- 效价-
- Ig类型IgG
- 纯化方式抗原特异性亲和纯化
- 标记物无标记物
- 免疫原RPA012Mu01-S100钙结合蛋白(S100)重组蛋白
- 缓冲液成份0.01M 磷酸盐缓冲液(pH7.4,containing 0.05% Proclin-300,50% glycerol)
- 性状液体
- 浓度0.5mg/mL
- 且适物种Homo sapiens (Human,人), Rattus norvegicus (Rat,大鼠), Bos taurus; Bovine (Cattle,牛)
- 应用WB; IHC; ICC/IF
如果抗体需用于流式细胞术,请参见流式抗体。 - 下载英文说明书 中文说明书
- 规格20µl100µl200µl1ml10ml
- 价格¥ 583¥ 1361¥ 1944¥ 4860¥ 19440
- 欲了解实际交易价格和更多情况,请与当地经销商联系!
特异性
该抗体是针对S100的兔多克隆抗体。在免疫组织化学染色和免疫印迹实验中能识别S100。
用法
Western blotting: 0.01-2µg/mL;
Immunohistochemistry: 5-20µg/mL;
Immunofluorescence: 5-20µg/mL;
Optimal working dilutions must be determined by end user.
储存
经常使用则4°C保存。-20°C保存不超过两年。避免反复冻融。
稳定性
热稳定性以损失率显示。损失率是由加速降解试验决定,具体方法如下:在37°C孵育48小时,没有显著的降解或者沉淀产生。保质期内,在适当的条件下存储,损失率低于5%。
赠品
增值服务
相关产品
| 编号 | 适用物种:Mus musculus (Mouse,小鼠) | 应用(仅供研究使用,不用于临床诊断!) |
| RPA012Mu02 | S100钙结合蛋白(S100)重组蛋白 | Positive Control; Immunogen; SDS-PAGE; WB. |
| RPA012Mu01 | S100钙结合蛋白(S100)重组蛋白 | Positive Control; Immunogen; SDS-PAGE; WB. |
| PAA012Mu02 | S100钙结合蛋白(S100)多克隆抗体 | WB; IHC; ICC; IP. |
| PAA012Mu01 | S100钙结合蛋白(S100)多克隆抗体 | WB; IHC; ICC/IF |
| LAA012Mu71 | S100钙结合蛋白(S100)多克隆抗体(生物素标记) | IHC |
| SEA012Mu | S100钙结合蛋白(S100)检测试剂盒(酶联免疫吸附试验法) | Enzyme-linked immunosorbent assay for Antigen Detection. |
| LMA012Mu | S100钙结合蛋白(S100)等多因子检测试剂盒(流式荧光发光法) | FLIA Kit for Antigen Detection. |
参考文献
| 杂志 | 参考文献 |
| Brain Research | Vasoactive intestinal peptide protects against ischemic brain damage induced by focal cerebral ischemia in rats[ScienceDirect: S0006899311008663] |
| J Exp Neurosci | A New Technique for Collection of Cerebrospinal Fluid in Rat Pups[PubMed: 26056488] |
| PLoS One | Regulation of Nutritional Metabolism in Transition Dairy Cows: Energy Homeostasis and Health in Response to Post-Ruminal Choline and Methionine[pubmed:27501393] |
| brain research | Ellagic acid exerts protective effect in intrastriatal 6-hydroxydopamine rat model of Parkinson's disease: Possible involvement of ERβ/Nrf2/HO-1 signaling.[pubmed:28238669] |
| КиберЛенинка | Levels of neurotropic autoantibodies in patients with schizophrenia[article:n] |
| Biomed Research International | Epigallocatechin-3-Gallate Reduces Neuronal Apoptosis in Rats after Middle Cerebral Artery Occlusion Injury via PI3K/AKT/eNOS Signaling Pathway[Pubmed:29770336] |
| Metabolic Brain Disease | Trigonelline protects hippocampus against intracerebral Aβ (1–40) as a model of Alzheimer's disease in the rat: insights into underlying mechanisms[Pubmed: 30421246] |
| ВОЗМОЖНОСТЬ ПРОГНОЗИРОВАНИЯ ОСТРОЙ НЕСПЕЦИФИЧЕСКОЙ БОЛИ В НИЖНЕЙ ЧАСТИ СПИНЫ С ИСПОЛЬЗОВАНИЕМ СЫВОРОТОЧНЫХ …[] | |
| ВЛИЯНИЕ ХРОНИЧЕСКОГО ВВЕДЕНИЯ НЕЙРОЛЕПТИКОВ НА УРОВНИ НЕЙРОСПЕЦИФИЧЕСКИХ АУТОАНТИТЕЛ В КРОВИ У КРЫС[] |